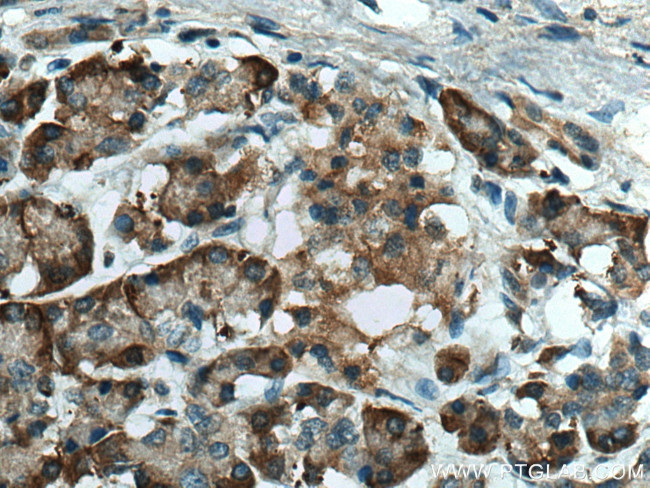
ERO1L Antibody in Immunohistochemistry (Paraffin) (IHC (P))

Search
Proteintech
ERO1L Polyclonal Antibody
{{$productOrderCtrl.translations['antibody.pdp.commerceCard.promotion.promotions']}}
{{$productOrderCtrl.translations['antibody.pdp.commerceCard.promotion.viewpromo']}}
{{$productOrderCtrl.translations['antibody.pdp.commerceCard.promotion.promocode']}}: {{promo.promoCode}} {{promo.promoTitle}} {{promo.promoDescription}}. {{$productOrderCtrl.translations['antibody.pdp.commerceCard.promotion.learnmore']}}
产品信息
12007-1-AP
种属反应
已发表种属
宿主/亚型
分类
类型
抗原
偶联物
形式
浓度
规格
纯化类型
保存液
内含物
保存条件
运输条件
产品详细信息
This antibody has no cross reaction to ERO1L.
Immunogen sequence: SGHGEEQPP ETAAQRCFCQ VSGYLDDCTC DVETIDRFNN YRLFPRLQKL LESDYFRYYK VNLKRPCPFW NDISQCGRRD CAVKPCQSDE VPDGIKSASY KYSEEANNLI EECEQAERLG AVDESLSEET QKAVLQWTKH DDSSDNFCEA DDIQSPEAEY VDLLLNPERY TGYKGPDAWK IWNVIYEENC FKPQTIKRPL NPLASGQGTS EENTFYSWLE GLCVEKRAFY RLISGLHASI NVHLSARYLL QETWLEKKWG HNITEFQQRF DGILTEGEGP RRLKNLYFLY LIELRALSKV LPFFERPDFQ LFTGNKIQDE ENKMLLLEIL HEIKSFPLHF DENSFFAGDK KEAHKLKEDF RLHFRNISRI MD (20-390 aa encoded by BC008674)
靶标信息
ERO1L (endoplasmic oxidoreductin-1-like protein) is localized in ER membrane as peripheral membrane protein on the lumenal side. Its association with ERP44 is essential for its retention in the ER and is unique in coupling oxygen reduction to de novo disulfides formation. The ERO1L enzyme is broadly distributed at low levels in several tissues with highest levels in the upper digestive tract and is stimulated by hypoxia via HIF-signaling. ERO1L generally exists as monomer, but has the ability to function as monomer or homodimer and interacts with PDILT. After translation, ERO1L gets n-glycosylated and the disulfide bonds constitute the redox-active center whereby the Cys-94/Cys-99 disulfide bond accepts an electron from P4HB followed by funneling the same to the active site disulfide Cys-394/Cys-397. ERO1L acts by oxidizing directly to P4HB/PDI isomerase through direct disulfide exchange and associates with ERP44. ERO1L is implicated in immunoglobulin folding, oxidative stress, release of unfolded cholera toxin from reduced P4HB/PDI upon Vibrio cholerae infection, and plays a key role in ER stress-induced CHOP-dependent apoptosis through inositol 1,4,5-trisphosphate receptor IP3R1 activation.
仅用于科研。不用于诊断过程。未经明确授权不得转售。
生物信息学
蛋白别名: Endoplasmic oxidoreductin-1-like protein; endoplasmic reticulum oxidation 1; Endoplasmic reticulum oxidoreductase alpha; Endoplasmic reticulum oxidoreductin-1-like protein; ero1; ERO1 homolog; ERO1-L; ERO1-L-alpha; ERO1-like protein alpha; Global ischemia-induced protein 11; Oxidoreductin-1-L-alpha; unnamed protein product
基因别名: ERO1-alpha; ERO1-L; ERO1-L-alpha; ERO1A; Ero1alpha; ERO1L; ERO1LA; Giig11; UNQ434/PRO865
UniProt ID: (Human) Q96HE7, (Mouse) Q8R180, (Rat) Q8R4A1
Entrez Gene ID: (Human) 30001, (Mouse) 50527, (Rat) 171562